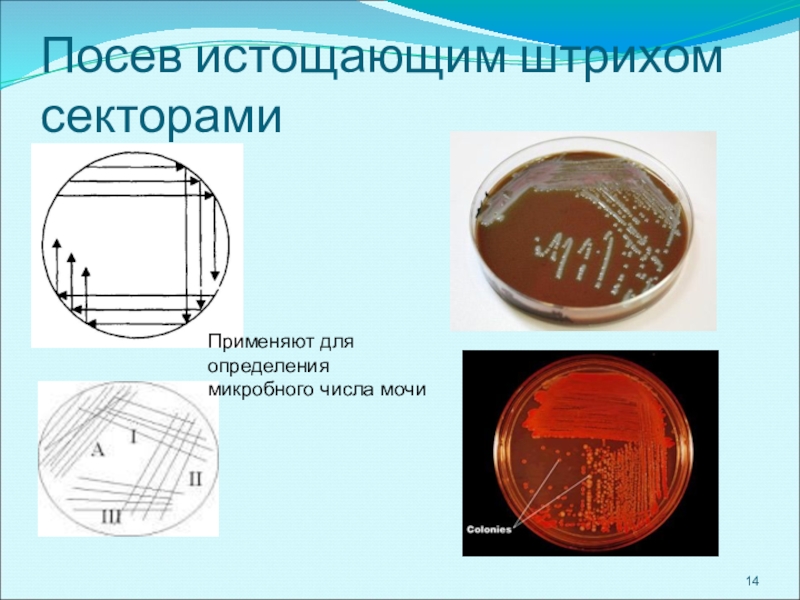

- Главная
- Разное
- Образование
- Спорт
- Естествознание
- Природоведение
- Религиоведение
- Французский язык
- Черчение
- Английский язык
- Астрономия
- Алгебра
- Биология
- География
- Геометрия
- Детские презентации
- Информатика
- История
- Литература
- Математика
- Музыка
- МХК
- Немецкий язык
- ОБЖ
- Обществознание
- Окружающий мир
- Педагогика
- Русский язык
- Технология
- Физика
- Философия
- Химия
- Шаблоны, фоны, картинки для презентаций
- Экология
- Экономика
Презентация, доклад по теме:Микробиология и вирусология
Содержание
- 1. Презентация по теме:Микробиология и вирусология
- 2. Цель работы:дать школьникам основы знаний по биобезопасности
- 3. Лаборатория микробиологии
- 4. Комната приема материала
- 5. Объекты исследованийПарфюмерно-косметические изделия.Пищевая продукция: молоко и молочные
- 6. Область исследованийОпределение синегнойной палочки (Pseudomonas aeruginosa)Определение
- 7. Предбоксник и бокс
- 8. Слайд 8
- 9. Слайд 9
- 10. Слайд 10
- 11. Метод Коха (метод серийных разведений)
- 12. Техника посева на питательные среды
- 13. Посев однократным истощающим штрихомПосев по секторам
- 14. Посев истощающим штрихом секторамиПрименяют для определения микробного числа мочи
- 15. Посев на скошенный агар, метод ШукевичаМесто
- 16. Посев уколом
- 17. Метод мембранных фильтров
- 18. Слайд 18
- 19. Бокс и микробиологическая комната
- 20. Рабочий процесс
- 21. Автоклавная
- 22. Средоварочная комната
- 23. Бокс для розлива стерильных питательных сред
- 24. Комната для подготовки стерильной посуды
- 25. Комната хранения питательных сред
- 26. Слайд 26
- 27. Слайд 27
- 28. Методы исследований
- 29. Микробиология молока и молочных продуктовМолоко: МАФАМ,
- 30. ПОРОКИ СВЕЖЕГО МОЛОКАГорький вкус (микрококки, маммококки, гнилотсные
- 31. ПАСТРИЗОВАННОЕ МОЛОКОПастеризация при 72-75 0С 15-20 сек.
- 32. ВИДЫ ПОРЧИ СЛИВОЧНОГО МАСЛАШтафф – изменение цвета
- 33. КОНДИТЕРСКИЕ ИЗДЕЛИЯЭто основной источник углеводов для человека.
- 34. ПОРЧА КОНИДИТЕРСКИХ ИЗДЕЛИЙ1. Взрыв, вызванный осмофильными дрожжами
- 35. МУЧНЫЕ КОНДИТЕРСКИЕ ИЗДЕЛИЯБольшое разнообразие состава и свойств.
- 36. МИКРОФЛОРА КОНСЕРВОВЭто пищевые стерильные продукты в герметично
- 37. СТЕРИЛИЗАЦИЯ КОНСЕРВОВВ малокислые консервы добавляют сорбиновую кислоту
- 38. ВИДЫ ПОРЧИ КОНСЕРВОВПлоскокислая порча: термофильные споробразующие бациллы,
- 39. Микробиология мяса и мясных продуктовМясо: МАФАМ, БГКП,
- 40. 1. ТемператураТермофильные виды. Зона оптимального роста равна
- 41. ПСИХРОФИЛЫЧаще всего обитают в морях – это
- 42. ПСИХРОФИЛЫChryseobacterium greenlandensis Ледники ГренландииВыдерживают t0 до –7,5 0С (t0 замерзания морской воды)
- 43. МЕЗОФИЛЫE. coliB. subtilis Proteus vulgaris Staphylococcus aureusОптимум 20-40 0С, минимальная t0 10-15 0С.
- 44. ТЕРМОФИЛЫИмеет энзим STABLE, позволяющий выживать при 135
- 45. ТЕРМОФИЛЫНавозные кучи Силосные ямыСухие клетки более
- 46. ВЛАЖНОСТЬ Н2О – среда для взаимодействия молекул
- 47. ОСМОТИЧЕСКОЕ ДАВЛЕНИЕ Концентрация веществ, растворенных во внешней
- 48. РЕАКЦИЯ СРЕДЫрН = – lg [Н+]. Концентрация
- 49. МОРФОЛОГИЯ БАКТЕРИЙ
- 50. СФЕРИЧЕСКИЕ БАКТЕРИИ (КОККИ) от греч. kokkos – зерно, ягода
- 51. ФОРМЫ КОККОВЛанцетовидная (коническая)(Diplococcus pneumoniae)Овальная(Peptostreptococcus)Удлиненная(Ruminococcus)Чечевицеобразная (Leuconostoc)Кофейные зерна(Neisseria gonorrhoeae)
- 52. РАЗМЕРЫ КОККОВВеличина варьирует от 0,2 до 2,5-3 мкм, чаще всего от 0,5 до 1 мкм
- 53. Среда обитания кокков
- 54. Значение кокковКруговорот веществ («мусорщики»)Силос Молочные продуктыСтимуляция роста растений
- 55. Кокки – возбудители болезнейСтрептодермияГнойный менингитСтафилококковые инфекцииКрупозная пневмонияПиодермия
- 56. МИКРОКОККИ Micrococcus luteus(типовой вид)Пигментация
- 57. Микрококки – причина порчи пищевых продуктовНекоторые микрококки
- 58. Патогенность микроккоковMicrococcus pyogenes Гнойные заболевания
- 59. ДИПЛОКОККИ
- 60. Болезни, вызываемые Diplococcus pneumoniae СептицемияКрупозная пневмонияПеритонитМенингит
- 61. Мелкие аэробные хрупкие диплококки, по форме как
- 62. Сапрофитные нейссерии из верхних дыхательных путей Neisseria subflavaNeisseria flavaNeisseria sр.
- 63. СТРЕПТОКОККИ StreptococcusБезвредные «молочные»Пиoгенные (гноеродные) – патогенныеФекальныеСтрептококки ротовой полости (оральные).
- 64. ЭНТЕРОКОККИ (Enterococcus) молочнокислые стрептококки
- 65. САРЦИНЫ Подрод Zymosarcina:Sarcina ventriculi,
- 66. Подрод Sarcinococcus (в воде, воздухе, в почве)Sarcina
- 67. СТАФИЛОКОККИ (Staphylococcus) St. aureus(золотистый стафилококк)(типовой вид)St.
- 68. ЦИЛИНДРИЧЕСКИЕ БАКТЕРИИ (ПАЛОЧКИ) от греч. bacteria
- 69. ДЛИНА ПАЛОЧЕК Длинные (> 3 мкм):Сlostridium botulinum(палочка
- 70. ФОРМА КОНЦОВ ПАЛОЧЕКЗакругленныеSalmonella typhi(сальмонелла)Shigella disenteriae(шигелла)Yersenia pestis(палочка чумы)Резанные краяЗаостренныеУтолщенныеВас. аnthracis(сибиреязвенная палочка)Суtophaga(цитофага)Corinebacterium diphtheriae(дифтерийная палочка)
- 71. ХАРАКТЕР РАСПОЛОЖЕНИЯ ПАЛОЧЕКSerracia marcescens (чудесная палочка) Поодиночно
- 72. ХАРАКТЕР РАСПОЛОЖЕНИЯ ПАЛОЧЕКПопарно(диплобактерии или диплобациллы)Pseudomonas aeruginosa(синегнойная палочка)
- 73. СПИРАЛЬНЫЕ БАКТЕРИИВибрионыVibrio cholerae(холерный вибрион) Spirillum volutans(спирилла) Спириллы
- 74. СпирохетыSpirochaeta plicatilis – пресные, морские и сточные
- 75. НЕОБЫЧНЫЕ ФОРМЫ БАКТЕРИЙТороидЗвездаMicrocyclus flavus Spirosoma StellaНитевидные бактерииБактероид
- 76. Слайд 76
- 77. МИКОПЛАЗМЫПатогенные для человека - M. pneumoniae (М.
- 78. ФИТОПАТОГЕННЫЕ МИКОПЛАЗМЫ Spiroplasma citri(спироплазма цитрусовая) Около 40 болезней растений
- 79. Слайд 79
- 80. Слайд 80
- 81. ОРНИТОЗ (пситтакоз) - попугайная болезнь (от
- 82. ХЛАМИДИИChlamidiya pneumoniae развивается в органах дыхания, в
- 83. НИТЧАТЫЕ (ТРИХОМНЫЕ) БАКТЕРИИ Веggiatoa alba
- 84. УЛЬТРАСТРУКТУРА БАКТЕРИИ1 - гранулы поли-β-оксимасляной кислоты; 2
- 85. ПОВЕРХНОСТНЫЕ СТРУКТУРЫ БАКТЕРИЙ (идентификационные признаки,
- 86. КАПСУЛААнатомически
- 87. ФУНКЦИИ КАПСУЛЫ1) защита от механических повреждений и
- 88. Слайд 88
- 89. МИКРОВОРСИНКИ (ФИМБРИИ)Ворсинки (фимбрии) короче и тоньше жгутиков,
- 90. Функции фимбрий главного типа1) придают бактериям свойство
- 91. Функции фимбрий альтернативного типасократительное движение за счет
- 92. Половые ворсинки или F-пили Их образование обусловлено
- 93. СТЕБЕЛЬКИСтебельковые бактерии имеют стебельки для прикрепления к
- 94. ШИПЫПолые цилиндрические выросты длиной до 3 мкм,
- 95. ЖГУТИКИ И ДВИЖЕНИЕ БАКТЕРИЙ Бактерии делятся на
- 96. По характеру расположения различают жгутики:1) полюсные (Саulobacter)
- 97. По количеству жгутиков бактерии делятся: 1) монотрихи
- 98. Слайд 98
- 99. СТРОЕНИЕ ЖГУТИКАФиламент (фибрилла, пропеллер) — полая белковая
- 100. СТРОЕНИЕ ЖГУТИКАУ Г–
- 101. СКОРОСТЬ ДВИЖЕНИЯ БАКТЕРИЙБольшинство бактерий в среднем за
- 102. СКОЛЬЗЯЩИЙ ТИП ДВИЖЕНИЯ(у миксококков, цитофаг, некоторых микоплазм,нитчатых серобактерий, цианобактерий) Cytophaga sр. и Myxococcus xanthus
- 103. ВРАЩАТЕЛЬНЫЙ ТИП ДВИЖЕНИЯКлетка спирохеты в продольном (А)
- 104. ТАКСИСЫ БАКТЕРИЙ1) хемотаксис (аттрактанты и репелленты):а) аэротаксис,
- 105. КЛЕТОЧНАЯ ОБОЛОЧКА («живая кожа») Состоит из клеточной стенки и ЦПМ
- 106. ФУНКЦИИ КЛЕТОЧНОЙ СТЕНКИ1) обеспечивает постоянство формы клетки,
- 107. ОКРАСКА ПО ГРАМУГанс Христиан Грам (1853-1938):окраска бактерий (1884)
- 108. СТРОЕНИЕ КЛЕТОЧНОЙ СТЕНКИ Г- БАКТЕРИЙПериплазма –
- 109. СОСТАВ КЛЕТОЧНОЙ СТЕНКИ ГР- БАКТЕРИЙРигидный слой: 1-2
- 110. СТРОЕНИЕ КЛЕТОЧНОЙ СТЕНКИ ГР+ БАКТЕРИЙ
- 111. ТЕЙХОЕВЫЕ КИСЛОТЫСодержание тейхоевых кислот высоко (у St.
- 112. Отличия грам+ и грам- бактерийграмположительныеМногослойный пептидогликан (40
- 113. ЦИТОПЛАЗМАТИЧЕСКАЯ МЕМБРАНА (ЦПМ) Обязательный структурный компонент
- 114. ЛИПИДЫ МЕМБРАНЫЦПМ бактерий состоит из двойного слоя
- 115. МЕМБРАННЫЕ БЕЛКИАсимметрично включены в двойной слой фосфолипидов,
- 116. ФУНКЦИИ ЦПМвнутренний осмотический барьер, регулирующий избирательное
- 117. ЗНАЧЕНИЕ ЦПМЦПМ – обязательный структурный компонент клетки, нарушение ее целостности приводит к потере жизнеспособности клетки
- 118. РАСПОЛОЖЕНИЕ МЕЗОСОМпериферические, образовавшимися в результате инвагинации ЦПМ,
- 119. Содержимое клетки, окруженное ЦПМ: цитозоль (70-80 % вода) + внутриклеточные структуры клетки
- 120. ВНУТРИКЛЕТОЧНЫЕ СТРУКТУРЫ БАКТЕРИЙРибосомыХроматофорыХлоросомыФикобилисомыКарбоксисомыГазовые вакуоли (аэросомы) Магнитосомы
- 121. РИБОСОМЫРазмер 16-18 нм. Состоят из РНК (60-65%)
- 122. РИБОСОМЫВ бактериальной клетке от 1500 до 50
- 123. ХРОМАТОФОРЫРазличаются по форме и расположению в клетке:
- 124. ХЛОРОСОМЫПродолговатые структуры шириной 25-70
- 125. ФИКОБИЛИСОМЫ КАРБОКСИСОМЫ
- 126. МАГНИТОСОМЫ ГАЗОВЫЕ ВАКУОЛИ В клетках
- 127. ВНУТРИЦИТОПЛАЗМАТИЧЕСКИЕ ВКЛЮЧЕНИЯ БАКТЕРИЙ Запасные вещества образуются в
- 128. Нуклеоид (хроматиновое тельце) - гигантская замкнутая
- 129. ДНК НУКЛЕОИДАДНК суперспирализована, образует 20-140 петель,соединенных с
- 130. ПЛАЗМИДЫПодразделяются на:1) трансмиссивные или конъюгативные факторы фертильности
- 131. Размножениебесполоеполовое
- 132. Питание бактерий В зависимости от источника получения
- 133. ДЫХАНИЕ БАКТЕРИЙ Дыхание (или биологическое окисление) микроорганизмов представляет
- 134. ОТНОШЕНИЕ БАКТЕРИЙ К КИСЛОРОДУОблигатные аэробные бактерии в
- 135. Ферменты1) простые ферменты (белки);2) сложные; состоят из
- 136. Антигены бактерий Стенка (наружная мембрана)
- 137. Инфекция — это совокупность биологических реакций, которыми
- 138. Классификация инфекцийбактериальные;вирусные;протозойные;микозы;микст-инфекции.По этиологииПо количеству возбудителеймоноинфекции;полиинфекции.легкие;тяжелые;средней тяжести.По тяжести
- 139. В зависимости от локализации возбудителя:При которой микроорганизмылокализуются
- 140. Выделяют следующие периоды инфекционных болезней:1.Инкубационный: от момента
- 141. Патогенность — это способность микроорганизмов, попадая в
- 142. Мезофильные аэробные и факультативно-анаэробные микроорганизмы (МАФАМ)
- 143. Энтеробактерии (семейство Еnterobacteriacea )Энтеробактерии -- грамотрицательные палочковидные
- 144. Представители семейства распространены в составе микрофлоры
- 145. Факультативные анаэробы. Антигены: 0-антиген – соматический,
- 146. Энтеробактерии имеют размеры 0,3-1,0 х 1,0-6,О мкм.
- 147. Кишечная инфекция — результат взаимодействия возбудителя с
- 148. Заболевания, вызываемые Е. соli, называются эшерихиозами. По
- 149. Роль кишечной палочки в нормальной микрофлореУ человека
- 150. Методы диагностики:
- 151. Чистая культура Escherichia coli. Окраска по методу Грама.
- 152. Палочка с закругленными концами, спор не образует; капсулу не образует; подвижна.E. сoliEscherichia сoli
- 153. Культивирование: Посев на питательные среды : 1
- 154. Светлые стрелки указывают на
- 155. Биохимические свойства E. сoli : 1.
- 156. Цветной ряд E. сoli
- 157. Сальмонеллезы (Salmonellosis, паратиф) Определение заболевания.
- 158. Выделяют следующие формы и варианты течения сальмонеллеза: 1.
- 159. Классификация возбудителей:Сем. Enterobacteriaceae Род: Salmonella Восприимчивые
- 160. Патогенез и факторы вирулентности:1. Основные пути заражения
- 161. Salmonella грамотрицательные палочки (Г-) рода Salmonella семейства
- 162. на среде Эндо – бесцветные или розоватые колонии
- 163. Биохимические свойства: обладают высокой сахаролитической активностью; «цветной
- 164. Схема исследования сальмонеллыпосев в
- 165. Серологический метод: используют РА (пробирочная и на
- 166. Синегнойная палочка Pseudomonas aeruginosa (синегнойная палочка) – грамотрицательная бактерия,
- 167. Клинические проявленияP. аeruginosa распространена повсеместно в природе,
- 168. Лабораторная диагностикаПосев: 100 см2 воды во флакон
- 169. Флюоресценция пиоцианинаинаПродукция сине-зелёного пигмента пиоцианина (слева) — важнейший диагностический признакКультуральные свойства P. аeruginosa
- 170. Стафилококк Представители данного рода — неподвижные грамположительныеПредставители данного рода —
- 171. Устойчивость к воздействиюВ природе стафилококки характеризуются высокой
- 172. Золотистый стафилококк (S. aureus) Слизистая оболочка носа,
- 173. СТАФИЛОКОКК ЗОЛОТИСТЫЙ (Staphylococcus aureus) Остеофолликулит
- 174. Лабораторная диагностика1. С предварительным накоплением Навеску продукта
- 175. ЛистерияМикроорганизмы рода Listeria представляют собой палочки с закруглёнными концами, одиночные или в коротких цепочках, (0,4-0,5 х 0,5-2 мкм).
- 176. Листерии во внешней средеЛистерии широко распространены во
- 177. Чем опасны листериозыЛистерия вызывает симптомы сильного пищевого
- 178. Диагностика листериозапосев в жидкую среду первичного обогащения
- 179. Культуральные свойства листерииНа
- 180. Борьба с патогенными бактериямиСоблюдение правил личной гигиеныПрививки
- 181. Спасибо за внимание
Слайд 1МИКРОБИОЛОГИЯ И ПРОФОРИЕНТАЦИОННАЯ РАБОТА В ШКОЛЕ В УСЛОВИЯХ ВВЕДЕНИЯ НОВОГО ОБРАЗОВАТЕЛЬНОГО
Слайд 2
Цель работы:дать школьникам основы знаний по биобезопасности и биозащите, а также
Основными задачами в работе со школьниками являются:
1. Создание дополнительной учебной базы для школьников на кафедре микробиологии.
2. Профориентационная работа в направлении «ВУЗ – школе, школа – ВУЗу».
3. Ознакомление школьников с разнообразием микроорганизмов и их основными биологическими свойствами.
4. Отработка практических навыков в условиях микробиологической лаборатории в направлении "Биозащита и биобезопасность".
5. Обучение школьников основам профилактики инфекционных заболеваний и повышению качества жизни.
6. Проведение школьниками научно-исследовательской работы по важнейшим для экономики РФ направлениям.
7. Создание школьниками научных проектов и участие их в выставках и конкурсах в области экологии, медицины и ветеринарии.
8. Участие школьников с научными проектами в фестивале технического творчества, посвященному всемирному дню науки, а также в днях инновации.Ка
Занятие со школьниками по курсу «Путешествие в мир бактерий»
для обучающихся 6 класса
ГБОУ СОШ № 623
Слайд 5Объекты исследований
Парфюмерно-косметические изделия.
Пищевая продукция: молоко и молочные продукты, яйца, мясо, колбасы
Вина.
Готовая продукция на предприятиях общественного питания.
Биологически активные добавки, травы.
Слайд 6
Область исследований
Определение синегнойной палочки (Pseudomonas aeruginosa)
Определение бактерий группы кишечной палочки (БГКП)
Выявление
Выявление бактерий рода Proteus
Определение патогенных микроорганизмов, в том числе Сальмонеллы (Salmonella typhimurium)
Выявление и определение количества коагулазоположительных стафилококков (Staphylococcus aureus)
Определение молочнокислых микроорганизмов (МКБ),
Определение дрожжей и плесневых грибов
Определение содержания плесневых грибов по Говарду
Определение и выявление количества сульфитредуцирующих клостридий,
Определение Bacillus cereus,
Определение количества мезофильных аэробных и факультивно-анаэробных микроорганизмов (мафам).
Определение остаточных количеств антибиотиков в продуктах животноводства.
Определение микробиологической розливостойкости в вине
определение промышленной стерильности консервов
Предупреждение картофельной болезни хлеба.
Определение и выявление количества Listeria monocytogenes
Слайд 11Метод Коха
(метод серийных разведений)
последовательное разведение исследуемого материала в жидкой
Слайд 15Посев на скошенный агар,
метод Шукевича
Место посева
культуры
по Шукевичу
Посев
однократным
штрихом
Метод Шукевича - применяется для получения чистой культуры протея и других микроорганизмов обладающих «ползущим» ростом. Посев исследуемого материала производят в конденсационную воду у основания скошенного агара . Подвижные микроорганизмы (протей) способны подниматься вверх по скошенному агару , неподвижные формы остаются расти внизу на месте посева. Пересевая верхние края культуры можно получить чистую культуру.
Слайд 29Микробиология молока и молочных продуктов
Молоко: МАФАМ, БГКП, сальмонелла, антибиотики, листерия
Масло:
Кисло-молочные продукты: МКБ, БГКП, сальмонелла, стафилококк, плесневые грибы, дрожжи.
Сыры: БГКП, сальмонелла, стафилококк, листерия, антибиотики
Мороженое: МАФАМ, БГКП, сальмонелла, стафилококк, листерия, антибиотики
Слайд 30ПОРОКИ СВЕЖЕГО МОЛОКА
Горький вкус (микрококки, маммококки, гнилотсные споровые и бесспоровые бактерии).
Прогорклый
Мыльный, щелочной вкус (психрофильные неспоровые палочки).
Несвойственный молоку запах (сырный, хлебный, тухлый, навозный, травяной): псевдомонас флюоресцирующий и кишечная палочка.
Тягучесть молока (без образования сгустка − басиллус лактис вискозус, с образованием сгустка – сливочный стрептококк, ацидофильная палочка).
Бродящее молоко (выделение газов – пена, дрожжевой, навозный запахи): БГКП.
Изменение цвета: красный (чудесная палочка),
желтый (бациллы), синий (псевдомонас пиоцианея).
Слайд 31ПАСТРИЗОВАННОЕ МОЛОКО
Пастеризация при 72-75 0С 15-20 сек. Остаточная микрофлора – 0,01-2
При пастеризации при 85-90 0С: термофильные молочнокислые палочки и споровые бактерии.
С оборудования в молоко попадают БГКП, психрофильные бактерии, мезофильные молочнокислые бактерии, термофильные палочки, дрожжи, уксуснокислые бактерии.
Пастеризованное молоко можно хранить ниже 10 0С не более 36-48 ч с момента пастеризации.
К пастеризованному молоку приближается сухое
молоко. В 1 г сухого молока высшего
сорта – не более 50 тыс. клеток
микробов, 1-го сорта – не более
100 тыс. клеток.
Слайд 32ВИДЫ ПОРЧИ СЛИВОЧНОГО МАСЛА
Штафф – изменение цвета и вкуса поверхностного слоя
Прогоркание (молочная плесень, псевдомонасы) начинается с поверхности, проникая внутрь, ярко-желтая окраска, едкий запах, сладковато-приторный вкус.
Горький вкус (флюоресцирующие и гнилостные бактерии, микрококки) – сырный вкус и гнилостный запах.
Нечистый, навозный запахи (БГКП).
Плесневение (молочная плесень, пеницилл, аспергилл, мукор, кладоспориум) → неприятный привкус, плесневелый запах.
Слайд 33КОНДИТЕРСКИЕ ИЗДЕЛИЯ
Это основной источник углеводов для человека. Сахаристые: конфеты, карамель, шоколад,
При производстве кондитерских изделий используется сахар и другие сладкие вещества (мед, ксилит, сорбит), патока, инвертный сироп, фруктово-ягодное пюре, сливочное масло, молоко, сливки, какао, ядра орехов, пектин, мука, красители, эссенции, кислоты, пряности - причина обсеменения разнообразными микроорганизмами.
Слайд 34ПОРЧА КОНИДИТЕРСКИХ ИЗДЕЛИЙ
1. Взрыв, вызванный осмофильными дрожжами (помадные конфеты, сбивные изделия).
2.
В кондитерские изделия, изготовленные с использованием сливочного масла,, может попасть стафилококк (St. аureus) → пищевое отравление.
Плесневые грибы, попавшие и развивающиеся на поверхности
мучных изделий, вырабатывают микотоксины → пищевые отравления.
В шоколаде могут встречаться МАФАнМ (мезофильные аэробные и факультативно-анаэробные микроорганизмы, БГКП, дрожжи,
плесневые грибы.
Слайд 35МУЧНЫЕ КОНДИТЕРСКИЕ ИЗДЕЛИЯ
Большое разнообразие состава и свойств. В зависимости от рецептуры
изготовленные из одного вида теста: печенье, галеты, крекеры, сдобное печенье, кексы;
изготовленные из теста и других масс: вафли, пряники, пирожные, торты.
Все мучные кондитерские изделия − это высококалорийные пищевые продукты, т.к. содержат легкоусвояемые углеводы, жиры, белки.
В мучных кондитерских изделиях всегда содержатся многочисленные микроорганизмы, даже в крекерах, которые выпекаются при 250 0С, остается в жизнеспособном состоянии масса бактериальных спор.
В мучных кондитерских изделиях могут содержаться:
КМАФАнМ − не более 5 • 104 КОЕ/г;
БГКП − не допускаются в 0,01 г;
St. aureus − не допускается в 0,01 г;
дрожжи − не более 100 КОЕ/г;
плесневые грибы − не более 50 КОЕ/г;
патогенные, в том числе сальмонеллы −
не допускаются в 25 г.
Савоярди для тирамсу
Слайд 36МИКРОФЛОРА КОНСЕРВОВ
Это пищевые стерильные продукты в герметично укупоренной таре.
Режим стерилизации зависит
Разные продукты подвергаются порче различными видами микроорганизмов, которые имеют различную устойчивость к нагреванию. Обычно консервы стерилизуют при 112-120 0С.
Фруктовые компоты, пюре, томатные пасты стерилизуют при 100 0С (их порчу вызывают нестойкие дрожжи и плесени). Кислая среда снижает устойчивость микробов к нагреванию, п.э. консервы с кислой томатной заливкой стерилизуют при 100-110 0С.
Слайд 37СТЕРИЛИЗАЦИЯ КОНСЕРВОВ
В малокислые консервы добавляют сорбиновую кислоту (0,1-0,5 %). Она безвредна
При производстве томатпродуктов и овощных соков добавляют низин, снижающий t0 стерилизации и улучшающий качество консервов.
Маринованные огурцы и кислые фруктовые компоты стерилизуют при 85-90 0С.
Но некоторое количество банок ( до 5 %) содержит остаточную микрофлору. Если остались жизнеспособные споры анаэробных бактерий → брожение → порча.
Если в банках споры аэробных бактерий, то в отсутствии кислорода они не прорастут → изменений в консервной массе не произойдет.
Слайд 38ВИДЫ ПОРЧИ КОНСЕРВОВ
Плоскокислая порча: термофильные споробразующие бациллы, превращающие углеводы в органические
Бомбажная порча (зеленый горошек, спаржа): термофильный сахаролитический клостридий, бациллус мезентерикус, бациллус полимикса.
Сероводородная порча (редко) – черная окраска содержимого, запах H2S (клостридий нигрификанс).
Бомбаж, вызванный мезофильными бактериями: клостридии спорогенез и путрификум (при рН 6 и выше).
Слайд 39Микробиология мяса и мясных продуктов
Мясо: МАФАМ, БГКП, Сальмонелла, антибиотики, листерия
Колбасы: БГКП,
Колбасы варенные: МАФАМ, БГКП, Сальмонелла, Стафилококк, клостридии, листерия
Слайд 401. Температура
Термофильные виды. Зона оптимального роста равна 50-60°С, верхняя зона задержки
Психрофильные виды (холодолюбивые) растут в диапазоне температур 0-10°С, максимальная зона задержки роста 20-30°С. К ним относит большинство сапрофитов, обитающих в почве, пресной и морской воде. Но есть некоторые виды, например, иерсинии, психрофильные варианты клебсиелл, псевдомонад, вызывающие заболевания у человека.
Мезофильные виды лучше растут в пределах 20-40°С; максимальная 43-45°С, минимальная 15-20°С. В окружающей среде могут переживать, но обычно не размножаются. К ним относится большинство патогенных и условно-патогенных микроорганизмов.
2. Реакция среды
3. Влажность среды
4. Свет
5. Концентрация растворенных веществ в среде
ВЛИЯНИЕ ФАКТОРОВ ВНЕШНЕЙ СРЕДЫ НА МИКРООРГАНИЗМЫ
Слайд 41ПСИХРОФИЛЫ
Чаще всего обитают в морях – это Г- палочки, имеющие особые
свойства мембран (Pseudomonas, Vibrio).
В антарктических и арктических почвах, озерах, ледниках, в ледяных
пещерах и в верхних слоях атмосферы преимущественно в холодных
условиях с неустойчивым температурным режимом встречаются
Г+ кокки и палочки (Arthrobacter, Corynebacterium, Kurthia,
Brevibacterium, Cellulomonas).
Слайд 42ПСИХРОФИЛЫ
Chryseobacterium greenlandensis
Ледники Гренландии
Выдерживают t0 до –7,5 0С (t0 замерзания морской
Слайд 43МЕЗОФИЛЫ
E. coli
B. subtilis
Proteus vulgaris
Staphylococcus aureus
Оптимум 20-40 0С, минимальная
Слайд 44ТЕРМОФИЛЫ
Имеет энзим STABLE, позволяющий выживать при 135 0С
(гидротермальные источники, серные
Гидротермальные
источники
Staphylothermus marinus
Серный вулукан Даллол
(Эфиопия)
Слайд 45ТЕРМОФИЛЫ
Навозные кучи
Силосные ямы
Сухие клетки более устойчивы к высокой
Споры устойчивее к t0, чем вегетативные клетки
Низкая рН усиливает действие высокой t0
Слайд 46ВЛАЖНОСТЬ
Н2О – среда для взаимодействия молекул разных размеров.
Структура воды, в
контролирует все жизненно важные процессы в клетке:
- действие ферментов и регуляцию их активности,
- ассоциацию и диссоциацию органелл,
- структуру мембран и их функционирование.
Небольшие изменения в концентрации растворенных веществ и активности
воды → значительные физиологические изменения в клетках.
В микроорганизмах 85% Н2О.
Treponema pallidum погибает на воздухе мгновенно, Vibrio cholerae – через 2 суток, дифтерийная палочка – через 30 дней, туберкулезна палочка – через 3 месяца, цисты азотобактера – через 10 лет.
При относительной влажности среды ниже 30% жизнедеятельность большинства бактерий прекращается.
Слайд 47ОСМОТИЧЕСКОЕ ДАВЛЕНИЕ
Концентрация веществ, растворенных во внешней среде, определяет
осмотическое давление
раствора, то Н2О поступает в клетку. Чем выше Р, тем < активность Н2О.
Осмотолерантные микробы растут в средах с высоким содержанием веществ
Осмофильные – в среде с повышенной концентрацией веществ.
Галофиты растут при высоких концентрациях NaCl (20-30 %).
Экстремальные галофилы (в Мертвом, Каспийском морях) - в концентрированных растворах NaCl. В клетках их много К+, а не Na+. В составе их ЦПМ липиды, связанные с эфиром, а не с жирными кислотами, клеточная стенка не содержит мурамовой кислоты. Соли поддерживают ферментативную активность.
Основной механизм адаптации к осмотическому состоянию среды - синтез микроорганизмами –
осмопротекторов (осмолитов, или совместимых растворителей) — низкомолекулярных органических веществ, концентрация которых в цитоплазме уравновешивает внешнее давление
Слайд 48РЕАКЦИЯ СРЕДЫ
рН = – lg [Н+]. Концентрация Н+ в чистой воде
Концентрация Н+ воздействует на ионное состояние и на доступность для организма многих метаболитов и неорганических ионов:
концентрация Н+ непосредственно влияет на клетку, ее электрический заряд,
состояние мембраны, возможность протекания ОВР, а также косвенно,
определяя ионное состояние металлов, кислот, их доступность и токсичность.
рН влияет на стабильность и функции макромолекул в биологических
процессах. Изменение рН приводит к изменению заряда клеточных коллоидов, проницаемости ЦПМ, активности ферментов.
Каждый микроорганизм существует в определенных границах рН.
У большинства оптимум рН 6-7.
Слайд 51ФОРМЫ КОККОВ
Ланцетовидная (коническая)
(Diplococcus pneumoniae)
Овальная
(Peptostreptococcus)
Удлиненная
(Ruminococcus)
Чечевицеобразная
(Leuconostoc)
Кофейные зерна
(Neisseria gonorrhoeae)
Слайд 54Значение кокков
Круговорот веществ («мусорщики»)
Силос
Молочные продукты
Стимуляция роста растений
Слайд 55Кокки – возбудители болезней
Стрептодермия
Гнойный менингит
Стафилококковые инфекции
Крупозная пневмония
Пиодермия
Слайд 56 МИКРОКОККИ
Micrococcus luteus
(типовой вид)
Пигментация колоний
Диаметр 1-2 мкм,
делятся в
Пигменты – защитные функции
Оптимум - 25-30 °С. Устойчивы к высушиванию и нагреванию. Строгие аэробы.
Слайд 57Микрококки – причина порчи пищевых продуктов
Некоторые микрококки развиваются в рассолах →
В молоке выделяют сычужный
фермент → образование сгустка и
появлению пороков молока
(преждевременное свертывание,
загустение сгущенного молока с
сахаром, горький вкус). Некоторое
микрококки разлагают жиры и
вызывают прогорклый вкус продукта
Слайд 61Мелкие аэробные хрупкие диплококки, по форме как кофейные зерна,
не могут
растут лишь на мясной среде с кровью при высокой влажности,
температуре 35-37 °С, в атмосфере с 5-10% С02.
Семейство Neisseriaceae
Слайд 62 Сапрофитные нейссерии
из верхних дыхательных путей
Neisseria subflava
Neisseria flava
Neisseria sр.
Слайд 63СТРЕПТОКОККИ
Streptococcus
Безвредные «молочные»
Пиoгенные (гноеродные) – патогенные
Фекальные
Стрептококки ротовой полости (оральные).
Слайд 64 ЭНТЕРОКОККИ (Enterococcus) молочнокислые стрептококки кишечного происхождения, обнаруживаются в молочных
Str. faecalis
(фекальный стрептококк)
Специфический запах сыров
Str. faecium
(энтерококк фэциум)
Слайд 65 САРЦИНЫ
Подрод Zymosarcina:
Sarcina ventriculi,
Sarcina maxima
Подрод Methanosarcina:
Sarcina
(образует метан из СО2),
Sarcina barkeri
Подрод Urosarcina:
Sporosarcina urea
(превращает мочевину в соли аммония; клетки подвижны)
Слайд 66Подрод Sarcinococcus
(в воде, воздухе, в почве)
Sarcina alba, S. agilis, S. aurea,
S. bicolor, S. camea, S. candida,
S. citrea, S. flava, S. gigantea,
S. lutea, S. maxima, S. minuta,
S. mirabilis, S. mucosa, S. nivea,
S. rosea, S. ventriculi
S. lutea
S. aurantiaca
Слайд 67СТАФИЛОКОККИ (Staphylococcus)
St. aureus
(золотистый стафилококк)
(типовой вид)
St. epidermidis
менее патогенный
Возбудитель гнойных инфекций, вызывает
Открыты Л. Пастером и Огстеном (1880),
Подробно описал Розенбах (1884)
Слайд 68ЦИЛИНДРИЧЕСКИЕ БАКТЕРИИ (ПАЛОЧКИ) от греч. bacteria – палочка, лат. bacillum – палочка
Васillus
(бацилла)
Рseudomonas
(псевдомонас)
Сlostidium
(клостридий)
(гр. kloster – веретено)
Сhromobacterium
(хромобактерия)
Слайд 69ДЛИНА ПАЛОЧЕК
Длинные (> 3 мкм):
Сlostridium botulinum
(палочка ботулизма)
Вас. megaterium
Сl. tetani
(столбнячная
Короткие – 1 мкм
Yersenia pestis
(палочка чумы)
Очень короткие (< 1 мкм)
Еscherichia coli (БГКП)
(кишечная палочка)
Слайд 70ФОРМА КОНЦОВ ПАЛОЧЕК
Закругленные
Salmonella typhi
(сальмонелла)
Shigella disenteriae
(шигелла)
Yersenia pestis
(палочка чумы)
Резанные края
Заостренные
Утолщенные
Вас. аnthracis
(сибиреязвенная палочка)
Суtophaga
(цитофага)
Corinebacterium diphtheriae
(дифтерийная
Слайд 72ХАРАКТЕР РАСПОЛОЖЕНИЯ ПАЛОЧЕК
Попарно
(диплобактерии или диплобациллы)
Pseudomonas aeruginosa
(синегнойная палочка)
Цепочками
(стрептобакгерии или cтрептобациллы
Васillus аnthracis
(сибиреязвенная палочка)
Bifidobacterium longum
(бифидобактерия)
Под углом друг к другу
Слайд 73СПИРАЛЬНЫЕ БАКТЕРИИ
Вибрионы
Vibrio cholerae
(холерный вибрион)
Spirillum volutans
(спирилла)
Спириллы
Спирохеты
Тreponema
(бледная спирохета)
(лат. vibrare – дрожать)
(лат. spira – изгиб)
(лат. spira – изгиб,
гр. chaite – грива)
Слайд 74Спирохеты
Spirochaeta plicatilis – пресные, морские
и сточные воды,
Тreponema pallidum –
Т. macrodentium – зубная спирохета
(при кариесе зубов)
Слайд 75НЕОБЫЧНЫЕ ФОРМЫ БАКТЕРИЙ
Тороид
Звезда
Microcyclus flavus
Spirosoma
Stella
Нитевидные бактерии
Бактероид
Слайд 76
Micoplasma hominis
(микоплазма человеческая)
Micoplasma pneumoniae
17 видов, паразитирующих у человека в полости рта,
глотке, дыхательных путях, мочеполовых органах.
Мелкие размеры (между Е. соli и Т-фагами).
Отсутствует клеточная стенка, полиморфизм.
Нечувствительны к антибиотикам.
Высокая потребность в питательных веществах.
Живут в почвах, сточных водах, каменном угле и
горячих источниках, внутриклеточные паразиты
животных и человека. Могут вступать в симбиоз.
Слайд 77МИКОПЛАЗМЫ
Патогенные для человека - M. pneumoniae (М. Итон, 1944), вызывающая
респираторный
группа генитальных микоплазм: M. hominis, M. genitalium, M. fermentans и
Ureaplasma urealyticum, вызывающих поражение мочеполовых органов
(уреоплазмоз и микоплазмоз).
Уреаплазмы – особая и наиболее «популярная» разновидность патогенных для
человека микоплазм.
Micoplasma fermentans
Ureaplasma parvum
Слайд 78ФИТОПАТОГЕННЫЕ МИКОПЛАЗМЫ
Spiroplasma citri
(спироплазма цитрусовая)
Около 40 болезней растений
Слайд 79 РИККЕТСИИ
Форма риккетсий
(плеоморфизм)
Облигатные внутриклеточные паразиты.
Размножаются делением внутри клеток хозяина.
Встречаются у кровососущих насекомых.
Многие непатогенны, некоторые вызывают
риккетсиозы, сыпной тиф, различные лихорадки
(марсельская, волынская – траншейная или окопная
лихорадка, болезнь «кошачьих царапин», ку-).
Антропонозы – только сыпной тиф
и волынская лихорадка.
Слайд 80
Chlamidiya trachomatis
Хламидия может заразить
каждую ткань или орган
Облигатные внутриклеточные паразиты человека и животных, размножаются в цитоплазме клеток; «энергетические паразиты».
Вызывают трахому (воспаление конъюктивы и
роговицы – слепота) и воспаления дыхательных
путей (орнитозы). Chlamidiya trachomatis
у новорожденных - конъюнктивит, воспаления
носоглотки, среднего уха, бронхов и легких, вульвовагинит, миокардит. У женщин – цервицит, эндометрит, уретрит, оофорит,
холецистит. У мужчин – проктит, уретрит,
простатит.
Слайд 81ОРНИТОЗ (пситтакоз) - попугайная болезнь
(от лат. psittacus - попугай)
.
Острая
Симптомы: лихорадка, общая интоксикация, поражение легких, ЦНС.
Резервуар - домашние и дикие птицы: утки, индюшки; попугаи,
волнистые попугайчики.
Заболевание чаще встречается в холодное время года.
Заражение - аэрогенным (воздушно-пылевым) путем.
Иммунитет после острой инфекции кратковременный и нестойкий.
Эффективной вакцины для профилактики орнитоза не существует
Chlamydia psittaci
Слайд 82ХЛАМИДИИ
Chlamidiya pneumoniae развивается в органах дыхания, в сердце и сосудах
(воспаление
коронарных сосудов, ишемия ).
Заболевания, вызванные данным микроорганизмом - хламидиозы.
Пути распространения хламидий:
- половой путь (самый распространенный),
- контактно-бытовой способ,
- вертикальный,
- воздушно-капельный способ (Chlamidia pneumoniae).
Каждый год этим заболеванием инфицируется более 100 млн.человек в мире.
Chlamidiya pneumoniae
Слайд 83НИТЧАТЫЕ
(ТРИХОМНЫЕ) БАКТЕРИИ
Веggiatoa alba
Бактерии со слизистыми стебельками:
1
СТЕБЕЛЬКОВЫЕ БАКТЕРИИ
ПОЧКУЮЩИЕСЯ БАКТЕРИИ
Hyphomicrobium с двумя стебельками
Слайд 84УЛЬТРАСТРУКТУРА БАКТЕРИИ
1 - гранулы поли-β-оксимасляной кислоты;
2 - жировые капельки; 3
4 - тубулярные мезосомы;
5 - плазмиды; 6 - везикулярные мезосомы;
7 - хроматофоры; 8 - нуклеоид; 9 - рибосомы;
10 - цитоплазма; 11 - базальное тельце; 12 - жгутики;
13 - капсула; 14 - клеточная стенка;
15 - цитоплазматическая мембрана; 16 - мезосома;
17 - газовые вакуоли (аэросомы);
18 - ламеллярные мезосомы;
19 - гранулы полисахарида; 20 - гранулы волютина
(полифосфата).
Основные структуры бактериальной клетки
представлены в верхней части рисунка,
дополнительные, мембранные структуры,
имеющиеся у фототрофных и нефототрофных
бактерий, - в средней части,
а включения запасных веществ - в нижней части.
Слайд 85ПОВЕРХНОСТНЫЕ СТРУКТУРЫ БАКТЕРИЙ
(идентификационные признаки,
не жизненно необходимые компоненты бактерий)
1. Капсулы
2. Чехлы
3. Придатки бактериальной клетки:
а) микроворсинки (фимбрии)
б) стебельки
в) шипы
г) жгутики
Слайд 86 КАПСУЛА
Анатомически различают:
1) микрокапсулы – толщиной
2) макрокапсулы – толщиной более 0,2 мкм;
3) слизистый слой – вязкие, накапливающиеся
на поверхности клетки вещества.
По строению капсулы:
1) нормального строения;
2) содержащие поперечно-полосатые фибриллы
из целлюлозы;
3) сложные капсулы, состоящие из участков
полисахаридов и полипептидов;
4) прерывистые капсулы.
Химический состав капсул родо-, видо-
и штаммоспецифичен
Слайд 87ФУНКЦИИ КАПСУЛЫ
1) защита от механических повреждений и высыхания,
2) дополнительный осмотический барьер,
3) препятствие для проникновения токсических веществ, фагов,
4) защита от фагоцитоза, высоких концентраций кислорода,
5) оптимальная аэрация клеток,
6) пул катионов благодаря отрицательному заряду вещества капсулы,
7) источник запасных питательных веществ,
8) связь между соседними клетками в колонии,
9) прикрепление клеток к различным субстратам (дереву, стали, бетону, кафелю),
10) полисахариды капсулы являются антигенами,
11) вирулентность,
12) иммунологическая мимикрия (Yеrsenia pestis).
Слайд 88 ЧЕХЛЫ
Имеют тонкую структуру, иногда многослойны,
инкрустированы оксидами металлов
(железа – Leptothrix ochracea).
Они характеризуются сложным составом.
Рыжая муть на дне ручья и влажные комья ржавого цвета на берегу под хвощами — продукты жизнедеятельности железобактерий, из которых в будущем может сформироваться болотная руда.
Слайд 89МИКРОВОРСИНКИ (ФИМБРИИ)
Ворсинки (фимбрии) короче и тоньше жгутиков, (диаметр 3-10 нм,
длина
жёсткие цилиндры.
2. Встречаются в большом количестве (от 200 до нескольких тысяч) по
всей поверхности клеточной оболочки.
3. Расположены по всей клетке или полярно.
4. Обнаружены у подвижных и неподвижных клеток (Кlebsiella, Salmonella,
Shigella, Pseudomonas, Proteus).
5. Состоят из гидрофобного белка пилина.
(лат. fimbriae – нить, бахрома, волокно)
Слайд 90Функции фимбрий главного типа
1) придают бактериям свойство гидрофобности;
2) адгезивная (основная ф-ция):
3) каркас для крепления капсулы; 4) участвуют в транспорте метаболитов;
5) препятствие для прикрепления бактериофагов (вирусов);
6) межклеточные контакты.
Слайд 91Функции фимбрий альтернативного типа
сократительное движение за счет полярных фимбрий, подобное
амебоидному
осуществляет твитчинг (движение рывком, которое позволяет осуществить
тесный контакт «клетка-клетка» или «клетка-субстрат»;
2) дергающееся движение бактерий (медленное периодическое перемещение
клеток и колоний по поверхности плотной среды);
3) роль конъюгационного мостика;
4) секреция токсинов и факторов вирулентности в случае патогенов;
5) факторы патогенности (ворсинками кишечная палочка
прикрепляется к эпителию, гонококк – к поверхности слизистых оболочек).
Слайд 92Половые ворсинки или F-пили
Их образование обусловлено наличием полового F-фактора.
Это
длиной до 1,0-2,0 мкм, образованы белком пилином.
Формируются F-пили только у активно растущей клетки за 4-5 мин
и в течение такого же промежутка времени сохраняются на ее
поверхности, затем сбрасываются.
Слайд 93СТЕБЕЛЬКИ
Стебельковые бактерии имеют стебельки для прикрепления к субстрату.
Различают клеточные стебельки,
Asticcacaulis), и неклеточные стебельки, образованные слизью (Nevskia,
Planktomyces, Gallionella).
Стебельковые бактерии - широко распространённые водные организмы,
составляющие часть эпифитных микроорганизмов водорослей.
Asticcacaulis (х 20 000)
1 - Nevskia, 2 - Gallionella
Слайд 94ШИПЫ
Полые цилиндрические выросты длиной до 3 мкм, толщиной около 65 нм,
расширяются у основания, в количестве до 10 на клетку, легко удаляются
механически, состоят из белка спинина.
Обнаружены у некоторых неподвижных планктонных морских бактерий.
Слайд 95ЖГУТИКИ И ДВИЖЕНИЕ БАКТЕРИЙ
Бактерии делятся на неподвижные и подвижные.
1) скользящее,
2)
3) поступательное с помощью жгутиков (наиболее распространено). Движение бактерий:
Слайд 96По характеру расположения различают жгутики:
1) полюсные (Саulobacter) ;
2) подполюсные (или субполярные)
3) боковые (или латеральные) (Selenomonas ruminantium);
4) перитрихиальные жгутики по всей поверхности клетки (E. сoli);
5) смешанные жгутики (Аеrоmonas).
1
2
3
4
5
Слайд 97По количеству жгутиков бактерии делятся:
1) монотрихи – один жгутик (Vibrio),
2) политрихи – пучок из 2-50 жгутиков:
a) монополярные политрихи – лофотрихи (Pseudomonas),
б) биполярные политрихи – амфитрихи (Spirillum),
3) перитрихи – 50-1000 жгутиков (Cl. tetani, Proteus vulgaris).
Слайд 98 ЖГУТИКИ
Жгутики –
Жгутики легко отрываются от клетки при встряхивании.
Средняя длина жгутиков большинства бактерий 10-20 мкм.
Химический состав жгутиков довольно однообразен:
на 98 % - белок флагеллин из 16 аминокислот,
сходным с миозином мышечных клеток.
Жгутики могут составлять до 2% массы бактерий.
Жгутик вырастает за 10-15 мин.
Слайд 99СТРОЕНИЕ ЖГУТИКА
Филамент (фибрилла, пропеллер) — полая белковая нить, состоящая из флагеллина,
Крюк - более толстое, чем филамент, белковое (не флагеллиновое) образование.
Базальное тело (трансмембранный мотор).
Слайд 100 СТРОЕНИЕ ЖГУТИКА
У Г– бактерий 2 пары колец:
Слайд 101СКОРОСТЬ ДВИЖЕНИЯ БАКТЕРИЙ
Большинство бактерий в среднем за секунду проходят расстояние,
близкое
холерный вибрион при длине тела в 2 мкм проходит до 30 мкм/с.
Скорость движения бактерий не зависит от количества жгутиков
(монотрихи и лофотрихи движутся со скоростью 50-60 мкм/с, а перитрихи –
25-30 мкм/с), но зависит от характера расположения жгутиков (бактерии с
терминальным расположением жгутиков движутся быстрее, чем перитрихи)
и свойств среды, в которой находится клетка (вязкость, температура, рН,
осмотическое давление и т. д.).
Жгутики не являются жизненно
необходимым приспособлением
Слайд 102СКОЛЬЗЯЩИЙ ТИП ДВИЖЕНИЯ
(у миксококков, цитофаг, некоторых микоплазм,
нитчатых серобактерий, цианобактерий)
Cytophaga sр.
Слайд 103ВРАЩАТЕЛЬНЫЙ ТИП ДВИЖЕНИЯ
Клетка спирохеты в продольном (А) и поперечном (Б) разрезе:
1
4 - место прикрепления аксиальных фибрилл; 5 - пептидогликановый слой
клеточной стенки; 6 - ЦПМ
Слайд 104ТАКСИСЫ БАКТЕРИЙ
1) хемотаксис (аттрактанты и репелленты):
а) аэротаксис, б) осмотаксис;
Бактерии имеют специфические
2) вискозитаксис;
3) магнетотаксис (ферритин у магнитотропных бактерий в донных осадках);
4) термотаксис;
5) фототаксис.
Слайд 106ФУНКЦИИ КЛЕТОЧНОЙ СТЕНКИ
1) обеспечивает постоянство формы клетки,
2) обеспечивает поверхностный заряд,
3) поддерживает постоянство внутренней среды,
4) участвует в делении,
5) участвует в транспорте питательных веществ и секреции метаболитов,
6) противодействует тургорному давлению клеточного содержимого,
7) поддерживает анатомическую целостность,
8) обеспечивает способность к адсорбции фагов,
9) участвует в реакциях иммунитета,
10) контакт с внешней средой,
11) защита от неблагоприятных внешних воздействий.
Слайд 108СТРОЕНИЕ КЛЕТОЧНОЙ СТЕНКИ
Г- БАКТЕРИЙ
Периплазма – это пространство между внешней мембраной
стенки и ЦПМ, содержит муреин (1,2 до 20 % от массы стенки), белки (основные – мажорные и второстепенные – минорные), олигосахариды (осморегуляция клетки), неорганические вещества.
Слайд 109СОСТАВ КЛЕТОЧНОЙ СТЕНКИ ГР- БАКТЕРИЙ
Ригидный слой: 1-2 слоя
пептидогликана.
Пластичный слой:
липополисахариды (ЛПС) и белки,
толщина превышает размеры
ригидного слоя.
Компоненты пластичного слоя
расположены мозаично, образуют
дополнительную внешнюю
мембрану или переходят в капсулу.
Внешняя мембрана заряжена
отрицательно.
Состоит из пластичного и ригидного слоев
Слайд 111ТЕЙХОЕВЫЕ КИСЛОТЫ
Содержание тейхоевых кислот высоко
(у St. аureus – 25-40 %,
массы клетки).
Тейхуроновые кислоты образованы остатками
уроновых кислот и N-ацетилглюкозамина
ФУНКЦИИ:
1) как полианионы влияют на катионный обмен клетки (связывают Мg2+),
2) определяют поверхностный заряд клетки,
3) участвуют в регуляции активности автолитических гидролаз,
4) необходимы для роста клеточной стенки, деления, споруляции,
5) входят в состав рецепторов для некоторых бактериофагов,
6) главные поверхностные антигены Г+ бактерий.
Слайд 112Отличия грам+ и грам- бактерий
грамположительные
Многослойный пептидогликан
(40 - 90% массы клеточной
2. Тетрапептиды пептидогликана соединены пентаглициновыми мостиками
3. Есть тейхоевые кислоты
4. Нет наружной мембраны
5. Нет периплазматического пространства
грамотрицательные
Однослойный пептидогликан
(5 - 10% массы клеточной стенки)
2. Тетрапептиды соединены напрямую
3. Нет тейхоевых кислот
4. Есть наружная мембрана
5. Есть периплазмати-
ческое пространство
Слайд 113 ЦИТОПЛАЗМАТИЧЕСКАЯ МЕМБРАНА (ЦПМ)
Обязательный структурный компонент клетки. Составляет 8-15 % массы
клетки и в силу тургора прилегает к клеточной стенке бактерий.
При плазмолизе ЦПМ вместе с цитоплазмой отстает от клеточной стенки.
У микоплазм ЦПМ – наружная структура клетки.
Белки - 50-75%, липиды -15-45 %, углеводы - до 6 % (БЛК)
Слайд 114ЛИПИДЫ МЕМБРАНЫ
ЦПМ бактерий состоит из двойного слоя фосфолипидов (до 80 %
липидов клетки).
В состав мембран входят и нейтральные липиды, а также гликолипиды,
каротиноиды, менахиноны, убихиноны, сквален - предшественник
ланостерина у галофилов.
Свойства мембранных липидов:
находятся в жидкостно-кристаллическом состоянии,
способны к вращению и латеральному перемещению в мембране,
при понижении температуры кристаллизуются
(обеспечивается свобода белков, необходимая для транспорта электронов и
веществ через мембрану).
ФУНКЦИИ:
1) поддержание механической стабильности мембраны,
2) придание гидрофобных свойств,
3) обеспечение высокой эластичности ЦПМ,
4) кислые фосфолипиды создают «– » заряд ЦПМ (у E. coli).
Молекула типичного "двухвостого"
мембранного липида
Слайд 115МЕМБРАННЫЕ БЕЛКИ
Асимметрично включены в двойной слой фосфолипидов,
частично или полностью погружены
- интегральные белки, связанные гидрофобными взаимодействиями,
образуют скопления на его поверхности;
- периферические белки, связанные электростатически.
Белки и липиды могут быть связаны и ковалентно.
Белки ЦПМ различаются между собой по молекулярной массе и составу,
подразделяются на структурные и функциональные (ферменты).
ЦПМ – биохимически активная оболочка бактерий.
В ЦПМ – мелкие поры, которые не являются стабильными структурами,
а образуются в результате временных перестроек молекулярной
организации мембраны.
Слайд 116ФУНКЦИИ ЦПМ
внутренний осмотический барьер, регулирующий избирательное
поступление в
2) транспортная функция;
3) биосинтетическая активность (синтез мембранных фосфолипидов,
компонентов клеточной стенки и капсулы);
4) синтез белка на рибосомах, связанных с мембраной;
5) энергетическая функция (АТФ-азная активность);
6) дыхательная функция (локализованы окислительные ферменты и
ферменты транспорта электронов);
7) локализация фотосинтетического аппарата у пурпурных бактерий;
8) присоединение хромосомы и плазмид при их репликации.
Слайд 117ЗНАЧЕНИЕ ЦПМ
ЦПМ – обязательный структурный компонент клетки,
нарушение ее целостности приводит
Слайд 118РАСПОЛОЖЕНИЕ МЕЗОСОМ
периферические, образовавшимися в результате инвагинации ЦПМ,
(увеличивают
2) ядерные (нуклеидосомы), которые соединены с нуклеоидом;
3) формирующиеся у делящихся бактерий в зоне образования
поперечной перегородки и принимающие участие в клеточном делении
(истинные мезосомы).
Функциональная роль мезосом в бактериальной
клетке окончательно не изучена
Слайд 119Содержимое клетки, окруженное ЦПМ:
цитозоль (70-80 % вода) + внутриклеточные
Слайд 120
ВНУТРИКЛЕТОЧНЫЕ СТРУКТУРЫ БАКТЕРИЙ
Рибосомы
Хроматофоры
Хлоросомы
Фикобилисомы
Карбоксисомы
Газовые вакуоли (аэросомы)
Магнитосомы
Слайд 121РИБОСОМЫ
Размер 16-18 нм. Состоят из РНК (60-65%) и белка (35-40%).
Содержат
По аминокислотному составу белок рибосом прокариот сходен с гистонами
рибосом эукариот, в нем отсутствуют триптофан и серосодержащие
аминокислоты.
Бактериальные рибосомы осаждаются при ультрацентрифугировании со
скоростью 70S (1S –1 сверберг-единица – 10–3 см/с/ед. поля).
Распадаются на две субъединицы – 30S и 50S.
У эубактерий нет носика и лопастей, у архебактерий есть носик,
нет лопастей, у эукариот есть носик и лопасти.
Слайд 122РИБОСОМЫ
В бактериальной клетке от 1500 до 50 000 рибосом, количество их
Скорость роста клетки определяется скоростью образования рибосом,
в среднем за каждую секунду образуется около 5-10 рибосом.
Большая часть рибосом объединяется в полисомы - агрегаты, состоящие из рибосом, молекул иРНК и тРНК, которые связаны с ЦПМ или мембранными структурами. Полисомы прицепляются к веточкам иРНК, а последние к нитям ДНК и образуются комплексы рибосом, иРНК и ДНК.
Рибосомы – место синтеза белка
Слайд 123ХРОМАТОФОРЫ
Различаются по форме и расположению в клетке:
трубочки и пузырьки
Тhiocestis, Сhromatium),
система трубочек, расположенных параллельными рядами,
ветвящиеся сдвоенные мембранные пластины (выросты ЦПМ) –
тилакоиды, собранные в стопки параллельно клеточной стенке.
а - синезеленая водоросль Аnаbеnа; б - серная пурпурная бактерия
Chromatium mimttissimum; в - несерная пурпурная бактерия Rhodopseudomonas
viridis: 1 - клеточная стенка; 2 - плазматическая мембрана; 3 - нуклеоид;
4 - тилакоиды; 5 - хроматофоры
Слайд 124 ХЛОРОСОМЫ
Продолговатые структуры шириной 25-70 нм, длиной 100-150 нм,
окружены однослойной белковой мембраной толщиной 2-3 нм.
В них упорядоченно упакованы молекулы бактериохлорофиллов.
Слайд 125ФИКОБИЛИСОМЫ КАРБОКСИСОМЫ
Полусферические или палочковидные
гранулы, располагаются правильными
рядами на внешней поверхности
фотосинтетических мембран,
содержат фикобилипротеиды.
Anabaena spiroides
Это 4- или 6-тигранные включения,
окружены однослойной белковой
мембраной, содержат фермент
фиксации СО2 в цикле Кальвина –
РДФ-карбоксилазу (РУБИСКО).
Слайд 126МАГНИТОСОМЫ ГАЗОВЫЕ ВАКУОЛИ
В клетках бактерий, обладающих
магнитотаксисом.
Это
окруженные мембраной, разные по
форме, количеству и характеру в клетке.
(АЭРОСОМЫ)
Газовые вакуоли почвенной бактерии
Renobacter vacuolatum (х 70 000)
У водных и почвенных бактерий.
Cостоят из параллельных рядов газовых
пузырьков (сотоподобная структура),
окружены однослойной белковой мембраной
У Сlostridium образуют колпачки на спорах.
Регуляторы плавучести бактерий.
Слайд 127ВНУТРИЦИТОПЛАЗМАТИЧЕСКИЕ ВКЛЮЧЕНИЯ БАКТЕРИЙ
Запасные вещества образуются в клетке в результате обмена веществ,
их образование зависит от условий культивирования микробов.
Включения в ряде случаев отграничены от цитоплазмы белковой мембраной, т.е. находятся в осмотически неактивном состоянии.
По консистенции делятся на:
жидкие (поли-β-оксибутират),
полужидкие (сера),
твердые (гликоген).
С химической точки зрения:
- химически чистые вещества (сера),
- смеси.
1 - гранулы ПОМ; 2 - жировые капельки;
3 - включения серы; 4 - трубчатые тилакоиды;
5 - пластинчатые тилакоиды; 6 - пузырьки;
7 - хроматофоры; 8 - ядро (нуклеоид);
9 - рибосомы; 10 - цитоплазма;
11 - базальное тельце; 12 - жгутики;
13 - капсула; 14 - клеточная стенка;
15 - цитоплазматическая мембрана;
16 - мезосома; 17 - газовые вакуоли;
18 - ламеллярные структуры;
19 - гранулы полисахарида;
20 - гранулы полифосфата
Слайд 128Нуклеоид (хроматиновое тельце) -
гигантская замкнутая кольцевая молекула ДНК
Нуклеоид (лат. nucleus
Нуклеоид довольно четко отграничен
от цитоплазмы
В клетках прокариот может быть несколько копий нуклеоида:
2-9 (Вас. subtilis), 40 молекул ДНК в одном нуклеоиде (Аzotobacter vinelandii).
Бактериальная хромосома содержит до 5∙106 пар азотистых оснований
(геном человека – 2,9∙109). В ДНК нуклеоида до 4 000 генов.
Длина ДНК в развернутом состоянии около 1 мм (E. coli), у микоплазм - 0,25 мм,
у цианобактерий – до 3 мм.
Слайд 129ДНК НУКЛЕОИДА
ДНК суперспирализована, образует 20-140 петель,
соединенных с плотной центральной областью, состоящей
ответственной за поддержание компактной формы.
У большинства прокариот гистоны не обнаружены.
Нейтрализация «–» зарядов в ДНК у прокариот
осуществляется полиаминами (спермином и спермидином) и Мg2+.
Хромосома бактерий всегда связана с мембраной.
В центре нуклеоида суперспирализованные петли неактивной ДНК,
по его периферии – деспирализованные петли активной ДНК.
У бактерий процессы транскрипции и трансляции идут одновременно,
одна и та же молекула иРНК может быть
одновременно связана с ДНК и рибосомами.
Содержание пар оснований А+Т и Г+Ц в молекуле ДНК - постоянный
для данного вида организма важный диагностический признак.
Слайд 130ПЛАЗМИДЫ
Подразделяются на:
1) трансмиссивные или конъюгативные факторы фертильности
(F-плазмиды) передаются при конъюгации;
Осуществляют:
- собственный перенос,
- перенос хромосомы клетки-донора в клетку- реципиент;
- перенос неконъюгативной плазмиды
2) нетрансмиссивные (неконъюгативные)
(более 30 на клетку) могут передаваться реципиенту за
счет связывания с конъюгативной плазмидой.
Функции плазмид:
Регуляторные участвуют в компенсировании дефектов метаболизма
посредством встраивания в поврежденный геном и восстановления его функций.
2) Кодирующие приносят в бактериальную клетку генетическую
информацию, кодирующие новые свойства (антибиотикоустойчивость).
Могут присутствовать или отсутствовать в клетке, они контролируют не
жизненно важные свойства бактерий. Плазмиды могут объединяться друг с другом
или с фаговыми ДНК, образуя коинтеграты. , которые могут распадаться и
существовать автономно.
Происхождение плазмид: конъюгативные плазмиды – вирусы
Слайд 132Питание бактерий
В зависимости от источника получения углерода бактерии делят на:
1) аутотрофы
2) гетеротрофы;
3) метатрофы (используют органические вещества неживой природы);
4) паратрофы (используют органические вещества живой природы).
По источникам энергии микроорганизмы делят на:
1) фототрофы (способны использовать солнечную энергию);
2) хемотрофы (получают энергию за счет окислительно-восстановительных реакций);
3) хемолитотрофы (используют неорганические соединения);
4) хемоорганотрофы (используют органические вещества).
Слайд 133ДЫХАНИЕ БАКТЕРИЙ
Дыхание (или биологическое окисление) микроорганизмов представляет собой совокупность биохимических процессов,
БАКТЕРИИ
АЭРОБЫ
микроорганизмы, которые развиваются и размножаются в среде, содержащей свободный кислород.
АНАЭРОБЫ микроорганизмы, которые развиваются и размножаются в среде, не содержащей свободный кислород.
ФАКУЛЬТАТИВНЫЕ И ОБЛИГАТНЫЕ АНАЭРОБЫ И АЭРОБЫ
Слайд 134ОТНОШЕНИЕ БАКТЕРИЙ К КИСЛОРОДУ
Облигатные аэробные бактерии в основном собираются в верхней
Облигатные анаэробные бактерии собираются в нижней части.
Факультативные бактерии собираются в основном в верхнем слое и на всем
протяжении среды, так как от O2 не зависят. 4. Микроаэрофилы собираются в верхней части пробирки, но их оптимум —
малая концентрация кислорода. 5. Аэротолерантные анаэробы не реагируют на концентрации O2 и равномерно
распределяются по пробирке.
Слайд 135Ферменты
1) простые ферменты (белки);
2) сложные; состоят из белковой (активного центра) и
1) оксидоредуктазы (катализируют окислительно-восстановительные реакции между двумя субстратами);
2) трансферазы (осуществляют межмолекулярный перенос химических групп);
3) гидролазы (осуществляют гидролитическое расщепление внутримолекулярных связей);
4) лиазы (присоединяют химические группы по двум связям, а также осуществляют обратные реакции);
5) изомеразы (осуществляют процессы изомеризации, обеспечивают внутреннюю конверсию с образованием различных изомеров);
6) лигазы, или синтетазы (соединяют две молекулы, вследствие чего происходит расщепление пирофосфатных связей)
Виды пластического обмена
Белковый обмен характеризуется катаболизмом и анаболизмом. В процессе катаболизма бактерии разлагают белки под действием протеаз с образованием пептидов. Под действием пептидаз из пептидов образуются аминокислоты.
Углеводный обмен: у бактерий катаболизм преобладает над анаболизмом.
1) спиртовое (характерно для грибов);
2) пропионионово-кислое (характерно для клостридий, про-
пиони-бактерий);
3) молочнокислое (характерно для стрептококков);
4) маслянокислое (характерно для сарцин);
5) бутилденгликолевое (характерно для бацилл).
Липидный обмен осуществляется с помощью ферментов — липопротеиназ, летициназ, липаз, фосфолипаз.
Слайд 136
Антигены бактерий
Стенка (наружная мембрана) бактериальной клетки значительно плотнее, чем мембрана
Пути проникновения инфекционных антигенов в организм разнообразны:через поврежденную и иногда неповрежденную кожу; через слизистые оболочки носа, рта, ЖКТ, мочеполовых путей.
Пути распространения антигенов - кровь, лимфа, а также по поверхности слизистых оболочек.
В структуре бактериальной клетки различают жгутиковые (Н-), соматические (О-), капсульные (К-) и другие антигены.
Антигены сальмонеллы
Слайд 137Инфекция — это совокупность биологических реакций, которыми макроорганизм отвечает на внедрение
Среди бактерий по способности вызывать заболевание выделяют:
1) патогенные;
2) условно-патогенные;
3) сапрофитные.
Важнейшая особенность патогенных микробов состоит в их способности вырабатывать в пораженном организме ядовитые вещества, называемые токсинами.
Токсины:
Экзотоксины выделяются микробной клеткой в окружающую среду. Они представляют собой белковые вещества и разрушаются при нагревании свыше 70°С. Экзотоксины — высокоядовитые белки.
Эндотоксины микроорганизмами наружу не выделяются. При жизни микробной клетки они остаются внутри клетки и освобождаются только после ее гибели и разрушения клеточной оболочки.
Слайд 138Классификация инфекций
бактериальные;
вирусные;
протозойные;
микозы;
микст-инфекции.
По этиологии
По количеству возбудителей
моноинфекции;
полиинфекции.
легкие;
тяжелые;
средней тяжести.
По тяжести течения
По длительности
острые;
подострые;
хронические;
латентные.
По путям передачи
Горизонтальные
Вертикальные
воздушно-капельный путь;
фекально-оральный
контактный
трансмиссивный;
половой.
от матери к плоду (трансплацентарный);
от матери к новорожденному в родовом акте.
Артифициальные
(искусственные)
при инъекциях,
обследованиях,
операциях и т.д.
Слайд 139В зависимости от локализации возбудителя:
При которой микроорганизмы
локализуются в местном очаге
и не
всему организму.
ГЕНЕРАЛИЗОВАННУЮ ИНФЕКЦИЮ
экзогенные инфекции
возникают в результате заражения человека патогенными микроорганизмами, поступающими из окружающей среды с пищей, водой, воздухом, почвой, выделениями больного человека
При которой возбудитель распространяется по организму лимфогенным и гематогенным путем. При этом развивается бактериемия или вирусемия. Наиболее тяжелая форма — сепсис.
эндогенные инфекции вызываются представителями нормальной микрофлоры — условно-патогенными микроорганизмами
ОЧАГОВУЮ ИНФЕКЦИЮ
Слайд 140Выделяют следующие периоды инфекционных болезней:
1.Инкубационный: от момента проникновения возбудителя в организм
2.Продромальный: характеризуется появлением первых неясных общих симптомов. Возбудитель интенсивно размножается, колонизирует ткань, начинает продуцировать ферменты и токсины. Продолжительность — от нескольких часов до нескольких дней.
3.Разгар болезни: характеризуется появлением специфических симптомов. Возбудитель продолжает интенсивно размножаться, накапливаться, выделяет в кровь токсины и ферменты. Происходит выделение возбудителя из организма, поэтому больной представляет опасность для окружающих. В начале данного периода в крови обнаруживаются специфические антитела.
4.Исход
Летальный исход
Выздоровление (клиническое и микробиологическое)
Хроническое носительство
Слайд 141Патогенность — это способность микроорганизмов, попадая в организм, вызывать в его
К факторам вирулентности относят:
1) адгезию — способность бактерий прикрепляться к эпителиальным клеткам;
2) колонизацию — способность размножаться на поверхности клеток, что ведет к накоплению бактерий;
3) пенетрацию — способность проникать в клетки;
4) инвазию — способность проникать в подлежащие ткани.
5) агрессию — способность противостоять факторам неспецифической и иммунной защиты организма.
Слайд 143Энтеробактерии
(семейство Еnterobacteriacea )
Энтеробактерии -- грамотрицательные палочковидные бактерии семейства кишечных бактерий
Роды семейства Еnterobacteriacea :
Escherichia,
Salmonella,
Citrobacter,
Klebsiella,
Proteus,
Shigella и др.
Слайд 144
Представители семейства распространены
в составе микрофлоры человека,
животных,
в почве,
в воде;
могут вызывать заболевания у человека и животных.
Некоторые энтеробактерии вызывают заболевания у птиц, насекомых и растений.
Восприимчивы все виды сельскохозяйственных животных, включая птиц и пушных зверей, главным образом, молодняк; болеет человек.
Слайд 145Факультативные анаэробы. Антигены:
0-антиген – соматический, в наружной мембране
К-антиген - капсульный (протеин или полисахарид),
Н-антиген (белковый, жгутиковый).
Слайд 146Энтеробактерии имеют размеры 0,3-1,0 х 1,0-6,О мкм. Грамотрицательные палочки, с закругленными
Все энтеробактерии:
1) ферментируют глюкозу до кислоты или до кислоты и газа;
2) редуцируют нитраты в нитриты;
3) каталаза +, оксидаза -, OF-тест ++.
Слайд 147Кишечная инфекция — результат взаимодействия возбудителя с соответствующими структурами макроорганизма при
1) адгезии;
2) инвазии;
3) колонизации;
4) продукции экзо- и энтеротоксинов.
Слайд 148Заболевания, вызываемые Е. соli, называются эшерихиозами.
По антигенным и токсигенным свойствам
Условно-патогенные кишечные палочки — комменсалы (представители нормальной микрофлоры кишки), возбудители инфекций в виде сепсиса, перитонита, цистита.
Патогенные, или диареегенные, кишечные палочки, вызывающие энтеральные эшерихиозы (гастроэнтериты, колиты и др.).
Слайд 149Роль кишечной палочки в нормальной микрофлоре
У человека количество этих микроорганизмов не
Вред кишечной палочки
Большинство штаммов E. coli являются безвредными, однако серотип О157:Н7 может вызывать тяжёлые пищевые отравления у людей.
Некоторые штаммы кишечной палочки вызывают не только заболевания желудочно-кишечного тракта, но поражают также мочеполовую систему, провоцируют кольпит, цистит, простатит, менингит у младенцев, иногда становятся причиной развития гемолитически-уремического синдрома, перитонита, мастита, пневмонии и сепсиса.
Нарушения пищеварения, размножение патогенного серотипа кишечной палочки и дисбактериоз могут возникать из-за многих заболеваний пищеварительной системы, в особенности поджелудочной железы (панкреатиты) и кишечника (колиты, энтероколиты).
Слайд 152Палочка с закругленными концами, спор не образует; капсулу не образует; подвижна.
E.
Escherichia сoli
Слайд 153
Культивирование:
Посев на питательные среды :
1 г продукта или
пересев на дифференциально-диагностические среды (среда Эндо, среда Левина и др.);
2. Особенности выделения возбудителя:
факультативные анаэробы;
оптимальная температура 37oС;
срок культивирования 18-20 часов.
Слайд 154
Светлые стрелки указывают на лактозоотрицательные колонии (неокрашенные),
Колонии кишечной палочки на среде Эндо. Колонии имеют темно-красный с металлическим оттенком цвет вследствие расщепления лактозы (черные стрелки);
Культуральные свойства E. сoli :
Слайд 155
Биохимические свойства E. сoli :
1. Обладает высокой сахаролитической активностью;
ферментируют с образованием кислоты и газа – глюкозу, лактозу, маннит, не расщепляют сахарозу;
2. Протеолитические свойства –
желатин не разжижают,
сероводород не образуют,
образуют индол,
3. Редукция красителей - дают положительную реакцию Метил-рот с метиленовым красным (ярко-розового цвета), отрицательная реакция Фогес-Проскауэра (не образуют ацетоин).
Слайд 157 Сальмонеллезы (Salmonellosis, паратиф)
Определение заболевания.
Сальмонеллезы (Salmonellosis, паратиф)
У взрослых животных заболевание сопровождается абортами, истощением, лихорадкой, поносами, но чаще протекает без заметных клинических признаков.
У человека сальмонеллезы протекают чаще по типу пищевой токсической инфекции.
Сальмонеллы длительно сохраняются во внешней среде: в воде до - 5 мес, в мясе - около 6 мес (в тушках птиц более года), в молоке - до 20 дней, кефире - до 1 мес, в сливочном масле - до 4 мес, в сырах - до 1 года, в яичном порошке - от 3 до 9 мес, на яичной скорлупе - от 17 до 24 дней, в пиве - до 2 мес, в почве - до 18 мес.
Слайд 158Выделяют следующие формы и варианты течения сальмонеллеза:
1. острое
2. хроническое,
3.транзиторное.
При всех формах
Слайд 159
Классификация возбудителей:
Сем. Enterobacteriaceae
Род: Salmonella
Восприимчивые животные
все виды животных, особенно молодняк, включая
Слайд 160Патогенез и факторы вирулентности:
1. Основные пути заражения –
алиментарный,
аэрогенный,
возможно
2. Размножаются в тонком кишечнике и гематогенным и лимфагенными путями разносятся в паренхиматозные органы, где вновь размножаются.
3. При распаде их высвобождаются эндотоксины, которые вызывают патологические процессы.
Сальмонеллы образуют два вида токсинов: экзо- и эндотоксины.
Слайд 161Salmonella грамотрицательные палочки (Г-) рода Salmonella семейства Enterobacteriaceae, с закругленными концами,
Сложная антигенная структура:
1) соматический термостабильный О-антиген
2) жгутиковый термолабильный Н-антиген.
У многих представителей выявляют поверхностный Vi-антиген.
Слайд 163Биохимические свойства:
обладают высокой сахаролитической активностью;
«цветной ряд» (среды
сальмонеллы не разжижают желатин, образуют сероводород, не образуют индол;
дают положительную реакцию с метиловым красным: среда окрашивается в розово-красный цвет,
отрицательную реакцию Фогеса-Проскауэра – желтое окрашивание среды
Слайд 164
Схема исследования сальмонеллы
посев в жидкую среду первичного
накпления
Пересев в 2 жидкие среды вторичного
накопления (инкубация 24-48 ч при t 37 )
Пересев на плотные среды дифференциально-
диагностические среды (инкубация 24-48 ч при t 37 )
Микроскопия
Биохимические исследования
Слайд 165
Серологический метод:
используют РА (пробирочная и на стекле) для серотипизации полученного
Слайд 166Синегнойная палочка
Pseudomonas aeruginosa (синегнойная палочка) – грамотрицательная бактерия, которая вызывает заболевания у
Слайд 167Клинические проявления
P. аeruginosa распространена повсеместно в природе, почве, воде, растениях, животных
P. aeruginosa является для человека условно-патогенным организмом. Она никогда не поражает здоровые неповрежденные ткани. Локальная инфекция наиболее часто возникает на месте порезов и ожогов. P. aeruginosa может вызвать инфекцию мочевыводящих путей инфекцию глаз, инфекцию кожи и мягких тканей (раневые инфекции, дерматит, пиодермия). Часто P. aeruginosa обнаруживают при обследовании детей, страдающих отитом - воспалением среднего уха. К другим серьезным инфекциям, вызываемым синегнойной палочкой можно отнести пневмонию, эндокардит (заражение клапанов сердца), инфекции центральной нервной системы (менингит и абсцесс мозга), костно-мышечного аппарата (в т.ч. суставов) и желудочно-кишечного тракта.
Слайд 168Лабораторная диагностика
Посев: 100 см2 воды во флакон с 10 см3 концентрированной
Пересев: на среду Блеск, термостатируют при t 370 24 - 42 ч.
Результат: Pseudomonas aeruginosa - колонии бордового цвета, плоские с золотистым налетом, имеют запах жасмина.
Пересев: подозрительных колоний на среду Кинг А. Термостатируют 24 ч при t 370. Дополнительно, при комнатной t 20 ч.
Рseudomonas aeruginosa плоские, с шероховатой поверхностью, неровными краями и венчиком колонии имеют бурый оттенок – фенозин-положительные колонии.
При наличии атипичных, (феназин «-») колоний:
окраска по Граму: грамотрицательные палочки.
Биохомическое подтверждение:
Оксидазный тест: оксидазоположительные.
Пересев колоний на среду с мальтозой. Термостатируют 16-18ч при t370
Пожелтение макроколоний и подлежащей среды-реакция положительная.
– реакция положительная.
. Пересев колоний уколом в пробирку со средой Х,ю-Лейфсона. Термостатируют 24 ч при t370. Рseudomonas aeruginosa: изменение верхней части среды на желтый и оранжевое окрашивание нижних 2/3 столбика.
2. Пересев колоний в нитратную среду.
Термостатируют 24 ч при t 420. Рseudomonas aeruginosa: появление пузырьков газа в толще среды или пены на поверхности среды.
Слайд 169Флюоресценция пиоцианинаина
Продукция сине-зелёного пигмента пиоцианина (слева) — важнейший диагностический признак
Культуральные свойства
P.
Слайд 170Стафилококк
Представители данного рода — неподвижные грамположительныеПредставители данного рода — неподвижные грамположительные коккиПредставители данного рода — неподвижные грамположительные кокки,
Слайд 171Устойчивость к воздействию
В природе стафилококки характеризуются высокой устойчивостью к действию солнечного
Слайд 172Золотистый стафилококк
(S. aureus)
Слизистая оболочка носа, носоглотки, ротоглотки – излюбленное место
Стафилококк относится к условно-патогенным микроорганизмам и может вызывать заболевание только при определенных обстоятельствах. В первую очередь, это состояние иммунитета.
Стафилококк на слизистой носа
Слайд 174Лабораторная диагностика
1. С предварительным накоплением
Навеску продукта (1 г) или его
2. Без предварительного накопления.
0,1-0,2 см3 навески или его разведения вносят на поверхность ЖСА, инкубируют при t - 370С – 48 часов.
Учет. На ЖСА – колонии St.aureus белого, кремового или сетло-желтого цвета, в виде выпуклых дисков с ровными краями, окружены зоной лецитиназной активности (радужный венчик).
Подтверждение принадлежности к St. aureus
Пересев характерных колоний на скошенный агар t 37С – 24 ч.
Определение отношения окраски по Граму.
Способность коагулировать плазму.
Ферментировать мальтозу в анаэробных условиях.
Реакция плазмокоагуляции.
Реакция положительная:
++++ - плотный сгусток;
+++ - сгусток, имеющий небольшой отсек;
++ - сгусток в виде взвешенного мешочка.
Реакция отрицательная:
+ - отдельные нити.
Слайд 175Листерия
Микроорганизмы рода Listeria представляют собой палочки с закруглёнными концами, одиночные или в коротких
Слайд 176Листерии во внешней среде
Листерии широко распространены во внешней среде. Встречаются в
В организм человека листерия чаще всего попадает с зараженными продуктами, через желудочно кишечный тракт.
Слайд 177Чем опасны листериозы
Листерия вызывает симптомы сильного пищевого отравления. Рвота, тошнота, диарея,
Бактерии начинают активно размножаться и проникать вглубь, выделяют токсины, которые разрушают клетки организма. При этом может нанести не поправимый вред центральной нервной системе или головному мозгу. Листериоз нервной системы может протекать в виде менингита, энцефалита, менингоэнцефалита. Течение тяжелое. После перенесенного заболевания возможны остаточные явления в виде психических нарушений, отставания в психомоторном развитии, параличей. Наиболее частая форма листериоза у взрослых.
Заболевание крайне опасно для беременных женщин. Возбудитель может попасть через организм матери в зародыша и нанести ему непоправимый вред, вплоть до летального исхода.
Слайд 178Диагностика листериоза
посев в жидкую среду первичного
обогащения (инкубация 16-20 ч при
Пересев в жидкие среду вторичного
обогащения (инкубация 24-48 ч при t 37 )
Пересев на плотные среды дифференциально-
диагностические среды (инкубация 24-48 ч при t 37 )
Микроскопия
Биохимические, серологические исследования
Слайд 179
Культуральные свойства листерии
На средах Палкам и Оксфорд – коричнево-черные колонии, с
Гемолиз на кровяном агаре
Ферментация глюкозы, рамнозы
Слайд 180Борьба с патогенными бактериями
Соблюдение правил личной гигиены
Прививки и вакцины
Ультрафиолетовое облучение
Антибиотики и
Вещества-окислители (йод, хлор, перекись водорода)
Термическая обработка
(пастеризация, кипячение, стерилизация).

![Презентация по теме:Микробиология и вирусология РЕАКЦИЯ СРЕДЫрН = – lg [Н+]. Концентрация Н+ в чистой воде РЕАКЦИЯ СРЕДЫрН = – lg [Н+]. Концентрация Н+ в чистой воде = 10–7, рН = 7.Концентрация Н+](/img/tmb/3/268307/a952b6026a761567f708957f52dba3ca-800x.jpg)










































































































































